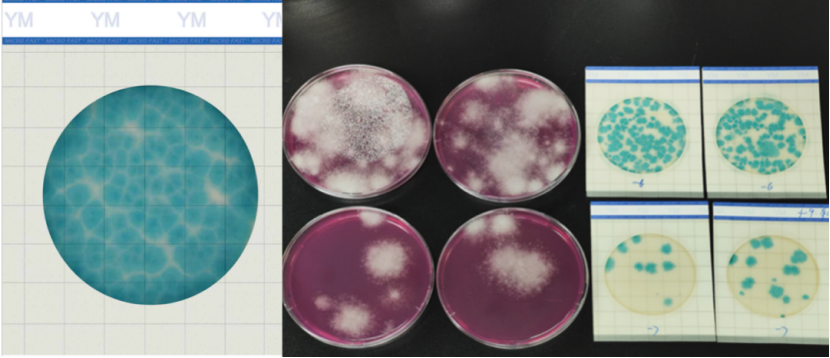
微信图片_20250825150811_224_192.png

2025-09-08 11:06浏览量:110

雪茄烟在存储和加工过程中均有可能发生霉变,进而影响产品的感官品质或产生霉菌毒素,然而预防和控制雪茄烟叶霉变的前提是能够快速检测霉菌含量并准确识别霉菌种类。传统的霉变检测及防控主要通过管理人员日常观察或嗅闻,不仅耗时耗力而且针对性不强。
因此,筛选适合实际生产过程中使用的霉菌快速计数测试片,并对霉变雪茄烟叶中的主要霉菌进行系统鉴定,对于提早发现烟叶霉变并进行针对性防控具有重要意义。
实验对比
山东烟草和中国烟草研究院选取生产过程中的霉变雪茄烟叶样品,通过比较 5 种市售测试片的霉菌计数结果,并与平板计数法计数结果进行比较,筛选适合实际应用的霉菌快速计数测试片。
最终结果
美正霉菌快速测试片综合检测效果最好,可满足日常检测的需要。

上述研究,综合霉菌形态学、ITS测序和MALDI-TOF MS鉴定结果,最终确定引起雪茄烟叶发酵过程中霉变发生的主要霉菌为土曲霉(Aspergillus terreus)和黄曲霉(Aspergillus flavus)。
参考文献:
杨绍鑫,黄阔,张鸽,等.雪茄烟叶中霉菌快速计数测试片的筛选及主要霉菌种类的鉴定[J].烟草科技,2024,57(10):68-75.DOI:10.16135/j.issn1002-0861.2024.0005.
创新方法,解锁霉菌酵母检测新路径
01.美正生物创新霉菌酵母测试片“快速显色技术”,解决了霉菌生长慢和蔓延、计数困难的难点
02.可满足多数样品在48h*内获得检测结果,满足工厂快速放行的需求
03.测试片显色清晰,“霉菌之间有边痕”,可有效解决培养基上霉菌蔓延无法计数的痛点,提高结果的准确性
04.测试片自身的结构优势可有效降低操作过程中的霉菌孢子污染
(*如有必要可适当延长培养时间至60h。)
美正生物基于强大的技术平台,携手用户共创高价值检验方法与创新产品,可实现定制化解决方案,攻克特定应用挑战。